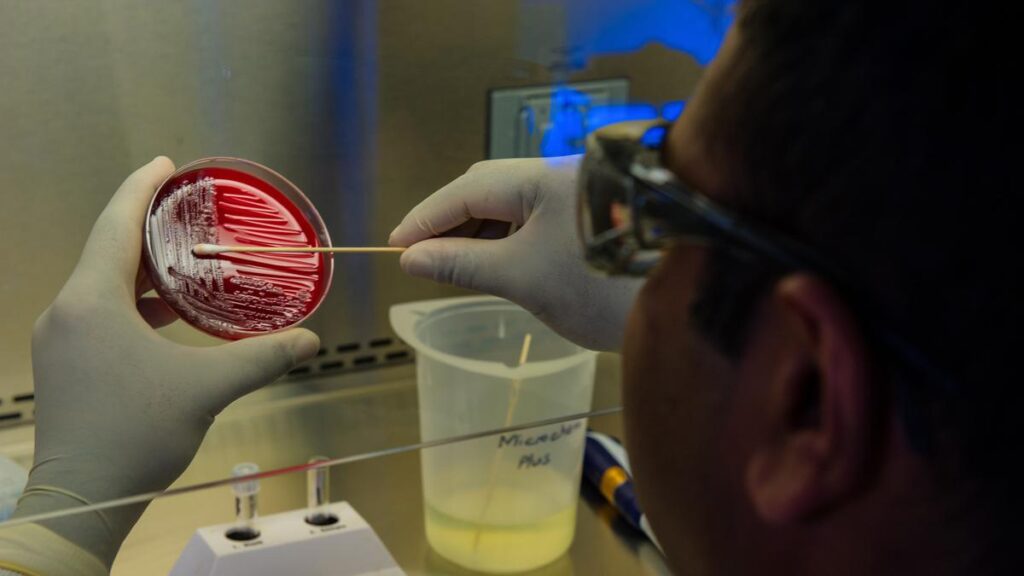
Biaya Tes DNA dan Prosedur yang Diperlukan, Pahami Manfaat dan Tujuannya

:strip_icc():format(webp)/kly-media-production/medias/3066347/original/010302800_1583210568-cdc-tQZ9nTjsQwU-unsplash.jpg)
Tes DNA memiliki tujuan dan kegunaan yang luas, mencakup berbagai aspek kesehatan, ilmu pengetahuan, forensik, dan hubungan keluarga. Berikut beberapa tujuan dan manfaat utama tes DNA:
1. Mendeteksi Kondisi Genetik
Salah satu tujuan utama tes DNA adalah mendeteksi adanya mutasi genetik yang dapat menyebabkan atau meningkatkan risiko berkembangnya kondisi atau penyakit genetik tertentu. Ini membantu dalam diagnosis, pengobatan dan pengelolaan penyakit genetik.
2. Mengetahui Risiko Kesehatan
Tes DNA dapat memberikan informasi mengenai risiko seseorang terkena penyakit tertentu, seperti penyakit jantung, kanker, diabetes, dan lainnya. Dengan mengetahui risiko-risiko tersebut, individu dapat mengambil tindakan pencegahan yang lebih baik dan menerapkan gaya hidup sehat.
3. Pengujian Genetik Prenatal
Tes DNA dapat digunakan untuk mengidentifikasi kelainan genetik pada janin yang belum lahir. Hal ini memberikan kesempatan bagi calon orang tua untuk mengambil keputusan yang tepat mengenai kesehatan janin.
4. Identifikasi Forensik
Dalam forensik, tes DNA digunakan untuk mengidentifikasi individu berdasarkan sidik jari genetiknya, seperti dalam kasus identifikasi korban kecelakaan atau kejahatan.
5. Hubungan Keluarga dan Keturunan
Tes DNA dapat mengkonfirmasi atau mengesampingkan ikatan keluarga dan keturunan. Hal ini berguna dalam membangun silsilah keluarga, mengetahui asal usul etnis, dan menemukan orang tua kandung dalam kasus adopsi.
6. Penelitian Ilmiah
Tes DNA menjadi alat penting dalam penelitian ilmiah untuk memahami variasi genetik dalam populasi, melacak migrasi manusia sepanjang sejarah, dan menemukan hubungan antara gen dan penyakit.
7. Pemilihan Terapi Personalisasi
Tes DNA dapat membantu dokter dalam memilih terapi yang lebih tepat dan efektif berdasarkan profil genetik individu pasien.
8. Pengembangan Obat dan Terapi Baru
Informasi genetik dari tes DNA dapat digunakan untuk mengembangkan obat dan terapi yang disesuaikan dengan kebutuhan genetik pasien.
9. Penyediaan Sumber Daya Medis yang Tepat
Tes DNA dapat membantu mengidentifikasi alergi terhadap obat-obatan atau kemungkinan reaksi terhadap berbagai obat.
10. Pemeliharaan Kesehatan
Tes DNA dapat memberikan wawasan tentang kecenderungan genetik seseorang terhadap respons terhadap pola makan, olahraga, dan gaya hidup, sehingga dapat membantu menjaga kesehatan dengan lebih efektif.
Namun, penting untuk diingat bahwa tes DNA juga memiliki aspek etika dan implikasi psikologis yang perlu dipertimbangkan. Hasil tes DNA dapat memberikan dampak yang signifikan bagi individu dan keluarga, baik dari segi kesehatan maupun identitas, sehingga keputusan untuk melakukan tes DNA perlu dipertimbangkan secara bijak dan dikonsultasikan oleh ahli genetika atau tenaga medis.